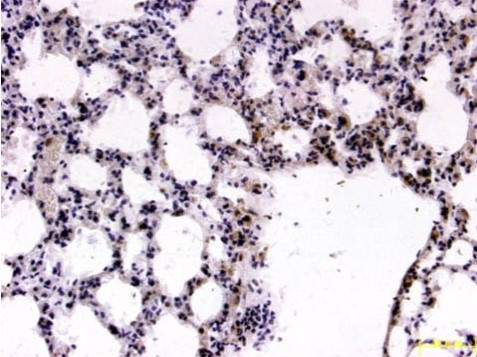
FOXP2 Antibody in Immunohistochemistry (Paraffin) (IHC (P))

Search
AbboMax
FOXP2 Polyclonal Antibody
{{$productOrderCtrl.translations['antibody.pdp.commerceCard.promotion.promotions']}}
{{$productOrderCtrl.translations['antibody.pdp.commerceCard.promotion.viewpromo']}}
{{$productOrderCtrl.translations['antibody.pdp.commerceCard.promotion.promocode']}}: {{promo.promoCode}} {{promo.promoTitle}} {{promo.promoDescription}}. {{$productOrderCtrl.translations['antibody.pdp.commerceCard.promotion.learnmore']}}
图: 1 / 2
FOXP2 Antibody (602-470) in IHC (P)


产品信息
602-470
种属反应
宿主/亚型
分类
类型
抗原
偶联物
形式
浓度
规格
纯化类型
保存液
内含物
保存条件
运输条件
产品详细信息
Positive control: Hela
Cellular location: Nucleus.
靶标信息
FOXP2 is a member of the forkhead/winged-helix (FOX) family of transcription factors. It is expressed in fetal and adult brain as well as in several other organs such as the lung and gut. The protein product contains a FOX DNA-binding domain and a large polyglutamine tract and is an evolutionarily conserved transcription factor, which may bind directly to approximately 300 to 400 gene promoters in the human genome to regulate the expression of a variety of genes. This gene is required for proper development of speech and language regions of the brain during embryogenesis, and may be involved in a variety of biological pathways and cascades that may ultimately influence language development. Mutations in this gene cause speech-language disorder 1 (SPCH1), also known as autosomal dominant speech and language disorder with orofacial dyspraxia. Multiple alternative transcripts encoding different isoforms have been identified in this gene.
仅用于科研。不用于诊断过程。未经明确授权不得转售。
篇参考文献 (0)
生物信息学
蛋白别名: alternatively spliced; alternatively spliced; 3' end may have intronic sequence; CAG repeat protein 44; DKFZp686H1726; Forkhead box protein P2; forkhead/winged-helix transcription factor; FOXP2; FOXP2-S; alternatively spliced; OTTHUMP00000196932; trinucleotide repeat containing 10; Trinucleotide repeat-containing gene 10 protein; truncated splice variant; unnamed protein product
基因别名: CAGH44; FOXP2; SPCH1; TNRC10
UniProt ID: (Human) O15409
Entrez Gene ID: (Human) 93986